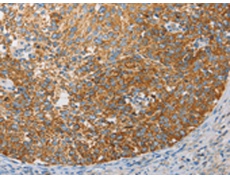
一抗

中文名稱(chēng): 兔抗APOBEC3G多克隆抗體
|
Background: |
This gene is a member of the cytidine deaminase gene family. It is one of seven related genes or pseudogenes found in a cluster, thought to result from gene duplication, on chromosome 22. Members of the cluster encode proteins that are structurally and functionally related to the C to U RNA-editing cytidine deaminase APOBEC1. It is thought that the proteins may be RNA editing enzymes and have roles in growth or cell cycle control. The protein encoded by this gene has been found to be a specific inhibitor of human immunodeficiency virus-1 (HIV-1) infectivity. |
|
Applications: |
ELISA, IHC |
|
Name of antibody: |
APOBEC3G |
|
Immunogen: |
Fusion protein of human APOBEC3G |
|
Full name: |
apolipoprotein B mRNA editing enzyme, catalytic polypeptide-like 3G |
|
Synonyms: |
A3G; ARCD; ARP9; ARP-9; CEM15; CEM-15; MDS019; bK150C2.7; dJ494G10.1 |
|
SwissProt: |
Q9HC16 |
|
ELISA Recommended dilution: |
1000-5000 |
|
IHC positive control: |
Human cervical cancer and human liver cancer |
|
IHC Recommend dilution: |
50-200 |

 購(gòu)物車(chē)
購(gòu)物車(chē) 幫助
幫助
 021-54845833/15800441009
021-54845833/15800441009